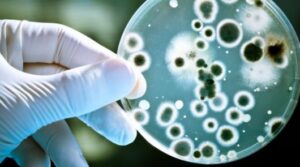

Os ácidos graxos de cadeia média (MCFAs) são ácidos graxos saturados de 6 a 12 carbonos, que ocorrem naturalmente como triglicerídeos de cadeia média na gordura do leite e em vários alimentos, especialmente coco, óleos de palma e óleos de sementes de Cuphea (Graham, 1989; Dierick et al., 2003; Marten et al., 2006).
Os ácidos graxos de cadeia média apresentam efeitos nutricionais e metabólicos específicos, incluindo digestão rápida, absorção passiva e oxidação obrigatória, tornando-os particularmente interessantes para a nutrição de animais jovens (Odle, 1997). Além de seus efeitos nutricionais como fonte de energia, suas atividades antimicrobianas, bem como um efeito protetor na microarquitetura intestinal, foram relatadas na literatura (Dierick et al., 2003). Também existem relatos de efeitos imunomoduladores da utilização de ácidos graxos de cadeia média nas dietas (Wang et al., 2006).
Normalmente, o conteúdo de ácidos graxos de cadeia média no óleo de coco é alto; da fração de óleo, aproximadamente 15% é composto de ácido caprílico (C8: 0), 15% de ácido cáprico (C10: 0) e de 41 à 56% de ácido láurico (C12: 0). Altos teores de ácido caprílico (6,2%), cáprico (7,0%) e láurico (41–55%) também podem ser encontrados no óleo de palmiste.
Devido aos seus efeitos antibacterianos, os MCFAs foram inicialmente usados na preservação de alimentos para animais, especificamente em silagem (Woolford, 1975) e rações (Freese et al., 1973). Muitos estudos in vitro evidenciaram que os MCFAs e seus monoglicerídeos são capazes de inativar bactérias, vírus e parasitas patogênicos. MCFAs foram considerados principalmente como tensoativos aniônicos, que, como resultado desta propriedade, apresentam seus efeitos antibacterianos (Mroz et al., 2006). A desestabilização da membrana pela incorporação de MCFAs na parede celular bacteriana e na membrana citoplasmática, bem como a inibição de lipases bacterianas, que são necessárias para a colonização da pele e da mucosa intestinal, podem ser os mecanismos principais no controle de bactérias patogênicas (Isaacs et al., 1995; Bergsson et al., 1998, 2002).